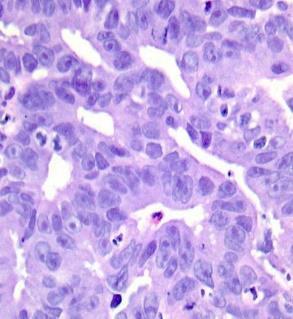

International Research Journal of Engineering and Technology (IRJET) e-ISSN: 2395-0056
Volume: 11 Issue: 08 | Aug 2024 www.irjet.net p-ISSN: 2395-0072
![]()

International Research Journal of Engineering and Technology (IRJET) e-ISSN: 2395-0056
Volume: 11 Issue: 08 | Aug 2024 www.irjet.net p-ISSN: 2395-0072
N. Muhilarasi1 , Dr.P.Indra2 , Prof.R.Yognapriya3
1PG Scholar., Communication Systems, Department of Electronics and Communication Engineering., Government College of Engineering Salem ,
2Assistant Professor., Department of Electronics and Communication Engineering., Government College of Engineering Salem ,
3Assistant Professor., Department of Electronics and Communication Engineering., Government College of Engineering Salem, ***
Abstract - Colorectal cancer is the second leading cause of cancer-related deaths worldwide, driven by multiple pathophysiological mechanisms such as abnormal cell proliferation, differentiation, resistance to apoptosis, local invasion by tumor cells, and distant metastasis. This malignancy poses a significant global health challenge, with early detection being paramount to improving patient outcomes. Histopathology images are the primary data source for pathologists, aiding in cancer diagnosis through detailed examination of tissue architecture, cell morphology,andabnormalgrowthpatterns.However,these imagesoftencontainartifactsanddistortionsduetovarious factors, complicating the extraction of relevant features from colorectal cancer images. In this proposed work, filters are employed for pre-processing, comparing three different types to determine the best method based on Mean Square Error (MSE), Peak Signal to Noise Ratio (PSNR), and StructuralSimilarityIndexMeasure(SSIM)values.
keywords: Histopathology image analysis, Progressive Switching Median filter, Wiener filter, Gaussian filter.
Colorectal cancer (CRC) is the fourth most common cancer, accounting for 10% of all new cancer cases,andthefifthleadingcauseofcancer-relateddeaths, resulting in approximately 550,000 deaths annually worldwide.While25%-50%ofCRCpatientsarediagnosed at an early stage but later experience recurrence or metastasis, Approximately 25% of colorectal cancer cases are identified at an advanced stage, a condition that is linked to a notably poor prognosis, reflected in a disheartening five-year overall survival rate of merely 14%..ThedevelopmentofCRCbeginswithchangesinthe normal colonic epithelium, including the formation of adenomatous polyps that can grow and multiply over time, accumulating genetic and epigenetic mutations. Whilenotallmalignantpolypsprogresstoinvasivecancer,
those that do can spread to neighboring tissues, particularlytheintestinalwall,andeventuallymetastasize todistantsitesviathelymphaticandcirculatorysystems.
CRC can be analyzed using various methods, including endoscopic, laparoscopic, MRI, CT, and others. Histopathological images (HIs) are based on the morphologicalandarchitecturalcharacteristicsdefinedby pathologists and exhibit distinct biological structures. HIs display a high degree of visual diversity in the connected patternsofspecificmicroscopicstructuresthroughoutthe tissue area. Numerous computerized techniques have been developed to process digitized histology images across the three main computer vision tasks: segmentation, feature extraction, and classification. All these tasks use an image as input. Segmentation extends beyond object detection by identifying specific object pixels rather than using a coarse bounding box. Feature extraction, part of the dimensionality reduction process, involves dividing an initial set of raw data into more manageable groups to simplify processing. Image classificationpredictstheclassortypeofanobjectwithin theinputimage,providingaclasslabelasoutput.
In this proposed work, dataset images undergo preprocessing to achieve high-precision images, enabling pathologists to diagnose patients with high accuracy, distinguishingbetweenmalignantandnormaltissues.
Authors: Jayesh George M, Perumal Sankar S Affiliation: Department of ECE, Vimal Jyothi Engineering College, Kannur, Kerala Preprocessing is a crucial step in image processing techniques, aimed at enhancing image quality by reducing unwanted distortions or highlighting specific features essential for further analysis. Mammogram images, in particular, present unique
© 2024, IRJET | ImpactFactorvalue: 8.226 | ISO9001:2008Certified Journal | Page60

International Research Journal of Engineering and Technology (IRJET) e-ISSN: 2395-0056
Volume: 11 Issue: 08 | Aug 2024 www.irjet.net p-ISSN: 2395-0072
challenges in interpretation, making effective preprocessing especially important. In their study, the authors evaluated various preprocessing filters for mammogram images. The median filter, when applied to noisy images, proved effective in eliminating salt-andpepper noise while preserving the integrity of the underlying image, as demonstrated in Figure 3. However, it was less effective in addressing Gaussian noise. Conversely, the adaptive median filter was found to be highly effective for noise separation without blurring edges, making it particularly suitable for mammogram image enhancement. This filter performs better against salt-and-pepper noise compared to speckle and Gaussian noise.Additionally,thestudyassessedtheperformanceof the Wienerfilter on noisyimages,yieldingspecific results discussed in the Proceedings of the 2017 IEEE International Conference on Circuits and Systems (ICCS2017).
The Effect of preprocessing filters on predictive performance in radiomics
Aydin Demircioğlu, All scans, including segmentations, were resampled to a uniform voxel size of 1 mm³ using spline interpolation. MRI series were normalized for intensity by centering all values to have a meanof0andastandarddeviationof1beforeprocessing. Incontrast,CTserieswerenotnormalizedsinceHUvalues were consistent across scans. Before feature extraction, several preprocessing filters were applied to the scans, including exponential, gradient, Laplacian-of-Gaussian (LoG), local binary pattern (in both two and three dimensions), logarithm, square, square-root, and wavelet filters. This work was published in European Radiology Experimental, with the article received on April 3, 2022, accepted on June 30, 2022, and published online on September1,2022.
Correction preprocessing method for cardiac scintography images using local adaptive filters
Eltayeb Wagiallah, Yasir Ahmed, Yousif Mohamed Y. Abdallah International Journal of Science and Research (IJSR) .This study introduces a robust method for estimating noise statistics in cardiac scintigraphy images. To achieve optimal image quality post-denoising, a novel low-order, local adaptive Gaussian Scale Mixture model is proposed, which addresses nonlinearities resulting from scattering. This experimental study presents a new approach for managing independently and identically distributed (IID) noise in cardiac images and aims to reduce data redundancy through advanced image processing techniques. The paper, titled Enhancing Feature Extraction from Histopathology Images of Colorectal Cancer through Comparative Analysis of Preprocessing Filters, is published in Volume 3, Issue 9, September 2014. It is available at www.ijsr.net, Paper ID:
SEP14660, under Creative Commons Attribution CC BY 2326. The study employs Matlab version R2009 to apply median and anisotropic filtering algorithms to ten different X-ray images, calculating their Mean Square Error(MSE)andPeakSignal-to-NoiseRatio(PSNR)values.
Peyman Rahmati, Ghassan Hamarneh, Doron Nussbaum, Andy Adler. This paper presents a computeraided approach designed to enhance suspicious lesions in digital mammograms. The developed algorithm improves uponthewidely-usedcontrast-limitedadaptivehistogram equalization (CLAHE) preprocessor filter by introducing thefuzzycontrast-limitedadaptivehistogramequalization (FCLAHE) filter. FCLAHE provides non-linear enhancement, effectively removing noise and intensity inhomogeneities in the background while preserving the natural gray level variations of mammographic images withintheregionsofinterest.
Evaluation of preprocessing methods on independent medical hyperspectral databases to improve analysis
Martinez-Vega,B.; Tkachenko,M.Sensors2022, 22, 8917. Published: 18 November This study assessed various preprocessing methods to enhance tumor detection across three hyperspectral imaging (HSI) databasesrelatedtocolorectal,esophagogastric,andbrain cancers. The preprocessing steps evaluated included spatialandspectralsmoothing,Min-Maxscaling,Standard NormalVariate(SNV)normalization,andamedianspatial smoothing technique. Calibrated data refer to datasets with minimal preprocessing, where only the removal of extreme spectral bands due to noise from the HS sensors and glare correction were performed to avoid includingproblematicpixelsinclassification.Filtereddata, on the other hand, involved applying a Gaussian filter to reduce noise. Min-Max scaling and SNV normalization were used to achieve a more uniform spectrum. Additionally, the median filter was employed to standardizepixelswithvaryingintensities.
The main objective of pre-processing technique is to improve or enhance the quality of image data that removesunwantednoisesortoboostsomeimagefeatures thatareimportantforfurtherprocessing.
Theseallaredonebyusingthefollowingtechniques,
I. Progressiveswitchingmedianfilter
II. wienerfilter

International Research Journal of Engineering and Technology (IRJET) e-ISSN: 2395-0056
Volume: 11 Issue: 08 | Aug 2024 www.irjet.net p-ISSN: 2395-0072
I. Progressive median switching filter:
TheProgressiveSwitchingMedian(PSM)filterisacuttingedge method for restoring severely damaged images without impulse noise. It functions as follows: Switching Scheme: To guarantee that just a portion of pixels those recognised as carrying impulse noise are filtered,animpulsedetectiontechniqueisusedbeforethe filteringprocedure.
Progressive Techniques: Using a series of iterations, both impulse detection and noise filtering are carried out gradually. By progressively enhancing the image and maintaining significant visual information, this method enhancestheefficacyofnoisereduction.
Progressive Techniques:
Iterative applications are used for both the noise filtering and impulse detection procedures. The noise-processed pixelsineachiterationaidintheimprovementofthenext. Evenforheavilydamagedimages,thisprogressivemethod guaranteesimprovedrestorationoutcomes.


Wiener filter:
TheWienerfilterperformstwomainfunctions-itinverts the blur of the image and removes extra noise. This method works exceptionally well for photographs that havebeen blurred bya recognisedlow-passfilter orhave experienced deterioration by a filter. It improves the overall clarity and quality of the image by successfully addressingproblemscausedbythesedistortions.

b) Block diagram of wiener filter
Wiener filtering is often performed in the frequency domain.
Steps:
Transform the noisy image and noise to the frequency domain (e.g., using the Fourier transform).
Compute the Wiener filter in the frequency domain:
H(f)=SX(f)+SN(f)SX(f)
where:
(H(f)) is the frequency response of the filter.
(S_X(f)) and (S_N(f)) are the power spectral densities of the true image and noise,respectively.
Inversetransformthefilteredresultbackto obtaintherestoredimage.
Aweightedaverageisappliedtothesurrounding ontheGaussiandistribution.Italsofunctionsasa realistic model to simulate the effects of a defocused lens and is especially good at eliminatingGaussiannoise.
A Gaussian kernel (or filter) defines the weights applied to neighboring pixels during the filtering process.Theweightsareprogressivelyreducedas the distance from the central pixel rises, with the central pixel receiving the maximum weight.The essential parameteristhestandarddeviation(σ), which controls the filter’s scope and smoothing effect.
ThefollowingistheimpulseresponseoftheonedimensionalGaussianfilter: h(t)=2πσ1e−2σ2t2
ThefrequencyresponseistheFouriertransform ofthisimpulseresponse.
Intwodimensions(forimages),it’stheproductof twosuchGaussians:


International Research Journal of Engineering and Technology (IRJET) e-ISSN: 2395-0056
Volume: 11 Issue: 08 | Aug 2024 www.irjet.net p-ISSN: 2395-0072
DATASET AND SOFTWARE TOOL USED
Table 1. Materials and Methods
Parameters Value
Dataset HISTOPATHOLOGYCOLON CANCERDATASET
Dataset
Number of images 5000
Tools used MATLAB2017a
In the above-mentioned dataset, there are total of 5000 images out of which 2500 are benign tissue and another 2500aremalignanttissueimagesofthecolon.
The proposed methods were applied on different digital images and some results are given below. Each figure indicates the original image, output image of three filter. By comparison of these three pre-processing techniques, progressive switching median filter provides betterresultswithlowMSE,highPSNRandSSIMvalues.
a) Original image


b) Gaussian filtered image c) Wiener filtered image

d) Median filtered image
Output images of Gaussian filter, Wiener filter, Progressive switching median filter.
To analyze the best filter for the preprocessing technique, it is important to note that the filtered image must have the least mean square error value, high Peak signal to noise ratio and high structural similarity index measure wants to be satisfied. It is know that the progressive switching median filter have satisfiedalltheseperformancecriteriawiththeleastmean squareerror,highstructuralsimilarityindexmeasureand highpeaksignaltonoiseratio.
Table 2: Comparison of MSE, PSNR and SSIM values for various images

In the realm of medical imaging, various types of noise can be introduced into original images, which necessitates the use of different filtering techniques to remove these disturbances. This paper focuses on eliminating detected masses from the original images
2024, IRJET | ImpactFactorvalue: 8.226 | ISO9001:2008Certified Journal | Page63

International Research Journal of Engineering and Technology (IRJET) e-ISSN: 2395-0056
through the application of several preprocessing techniques. Among the nonlinear filters evaluated, the progressive switching median filter demonstrated superior performance, evidenced by its lower Mean Square Error (MSE), higher Peak Signal-to-Noise Ratio (PSNR), and better Structural Similarity Index Measure (SSIM)values.
Lookingahead,thefurtherworkistosegmentandclassify these images to accurately determine whether they contain cancerous tissue. The goal is to enhance early detection capabilities, thereby potentially reducing the mortality rate associated with cancer by improving the accuracy of predictions and facilitating earlier intervention.
1) Dr. P. Indra, R.Yoganapriya, “Pre-Processing Techniques For Breast Cancer Detection In Mammography Images”, International Journal of Novel Research and Development (IJNRD), ISSN: 2456-4184,pp:a79-a83,Volume8,Issue7July2023.
2) Dr. P. Indra, R.Yoganapriya, “Optimizing Melanoma Skin Cancer Analysis through Pre-Processing Strategies”, International Journal of All Research Education and Scientific Methods (IJARESM), ISSN:2455-6211,pp:1498-1503.
3) Dr. P. Indra (2020), “Multilevel Tetro let transform based breast cancer classifier and diagnosis system for healthcare applications”, in the proceedings of Journal of Ambient Intelligence and Humanized Computing ISSN 1868-5137, J Ambient In tell Human Compute. https://doi.org/10.1007/s12652-02001755-z
4) Dr. P. Indra, (2014), “Classification of Micro Calcification in Digital Mammogram using Tetro let Transform”, in the Proceedings of the International Journal of Innovative Research & Advanced Studies (IJIRS), Vol 3, Issue 8, pages:398-410, ISSN 2319-9728onAugust2014.
5) Dr. P. Indra, (2014), “Mammogram Classification based on conventional Harr Transform”, in the Proceedings of the International Journal of Multidisciplinary Research and Advances in Engineering (IJMRAE), Vol 6 No IV, pages: 1-8, ISSN 0975-7074onOctober2014.
6) Dr. P. Indra, (2015), “Survey on Mammogram Image Classification CAD system” in the proceedings of Global Journal of Engineering and Applied Sciences (GJEAS)Vol4,Issue3,pages:54-56.
7) R. Yoganapriya , Prof .P. Indra., (2020). “Detection of massesindigitalmammogramusingnonlinearfilters” ,International Research Journal of Engineering and Technology(IRJET)Vol07,Issue12.
8) R.Ramani, Dr. N . Suthanthira Vanitha, S. Valarmathy , “The Pre Processing Techniques for Breast Cancer Detection in Mammography Images”, I.J. Image, GraphicsandSignalProcessing,2013,5,47-54.
9) Nithya. K, Aruna.A, Anandakumar.H, Anuradha.B. ”A Survey On Image Denoising Methodology On Mammogram Images” International journal of scientific & technology research volume 3,issue 11, november2014.
10) D. Sujitha Priya,Dr. B. Sarojini.”Breast Cancer Detection InMammogram Images Using RegionGrowing AndContour-BasedSegmentationtechnique “International Journal of Computer & Organization Trends–Volume3Issue8–Sep2013.
11) Aydin demircioglu “the effect of preprocessing filters on predictive performance inradiomics” Demircioğlu European Radiology Experimental ,Received: 3 April 2022 Accepted: 30 June 2022 published online: 01 September2022
12) Wagiallah 1,yasir ahmed 2, yousif mohamed y. abdallah3 , international journal of science and research (ijsr) “correction preprocessing method for cardiac scintography images using local adaptive filters”
13) Peyman rahmati1, Ghassan hamarneh2, Doron nussbaum3, and andy adler1 Stolz, W., et al. &Quot; Abcdruleofdermatoscopy-anewpracticalmethodfor early recognition of malignant-melanoma.& quot; EuropeanJournalofDermatology4.7 (1994).
14) Ng, Vincent TY, Benny YM Fung, and Tim K. Lee & quot; Determining the asymmetry of skin lesion with fuzzy borders " Computers in biology and medicine35.2(2005).
Volume: 11 Issue: 08 | Aug 2024 www.irjet.net p-ISSN: 2395-0072 © 2024, IRJET | ImpactFactorvalue: 8.226 | ISO9001:2008Certified Journal | Page64